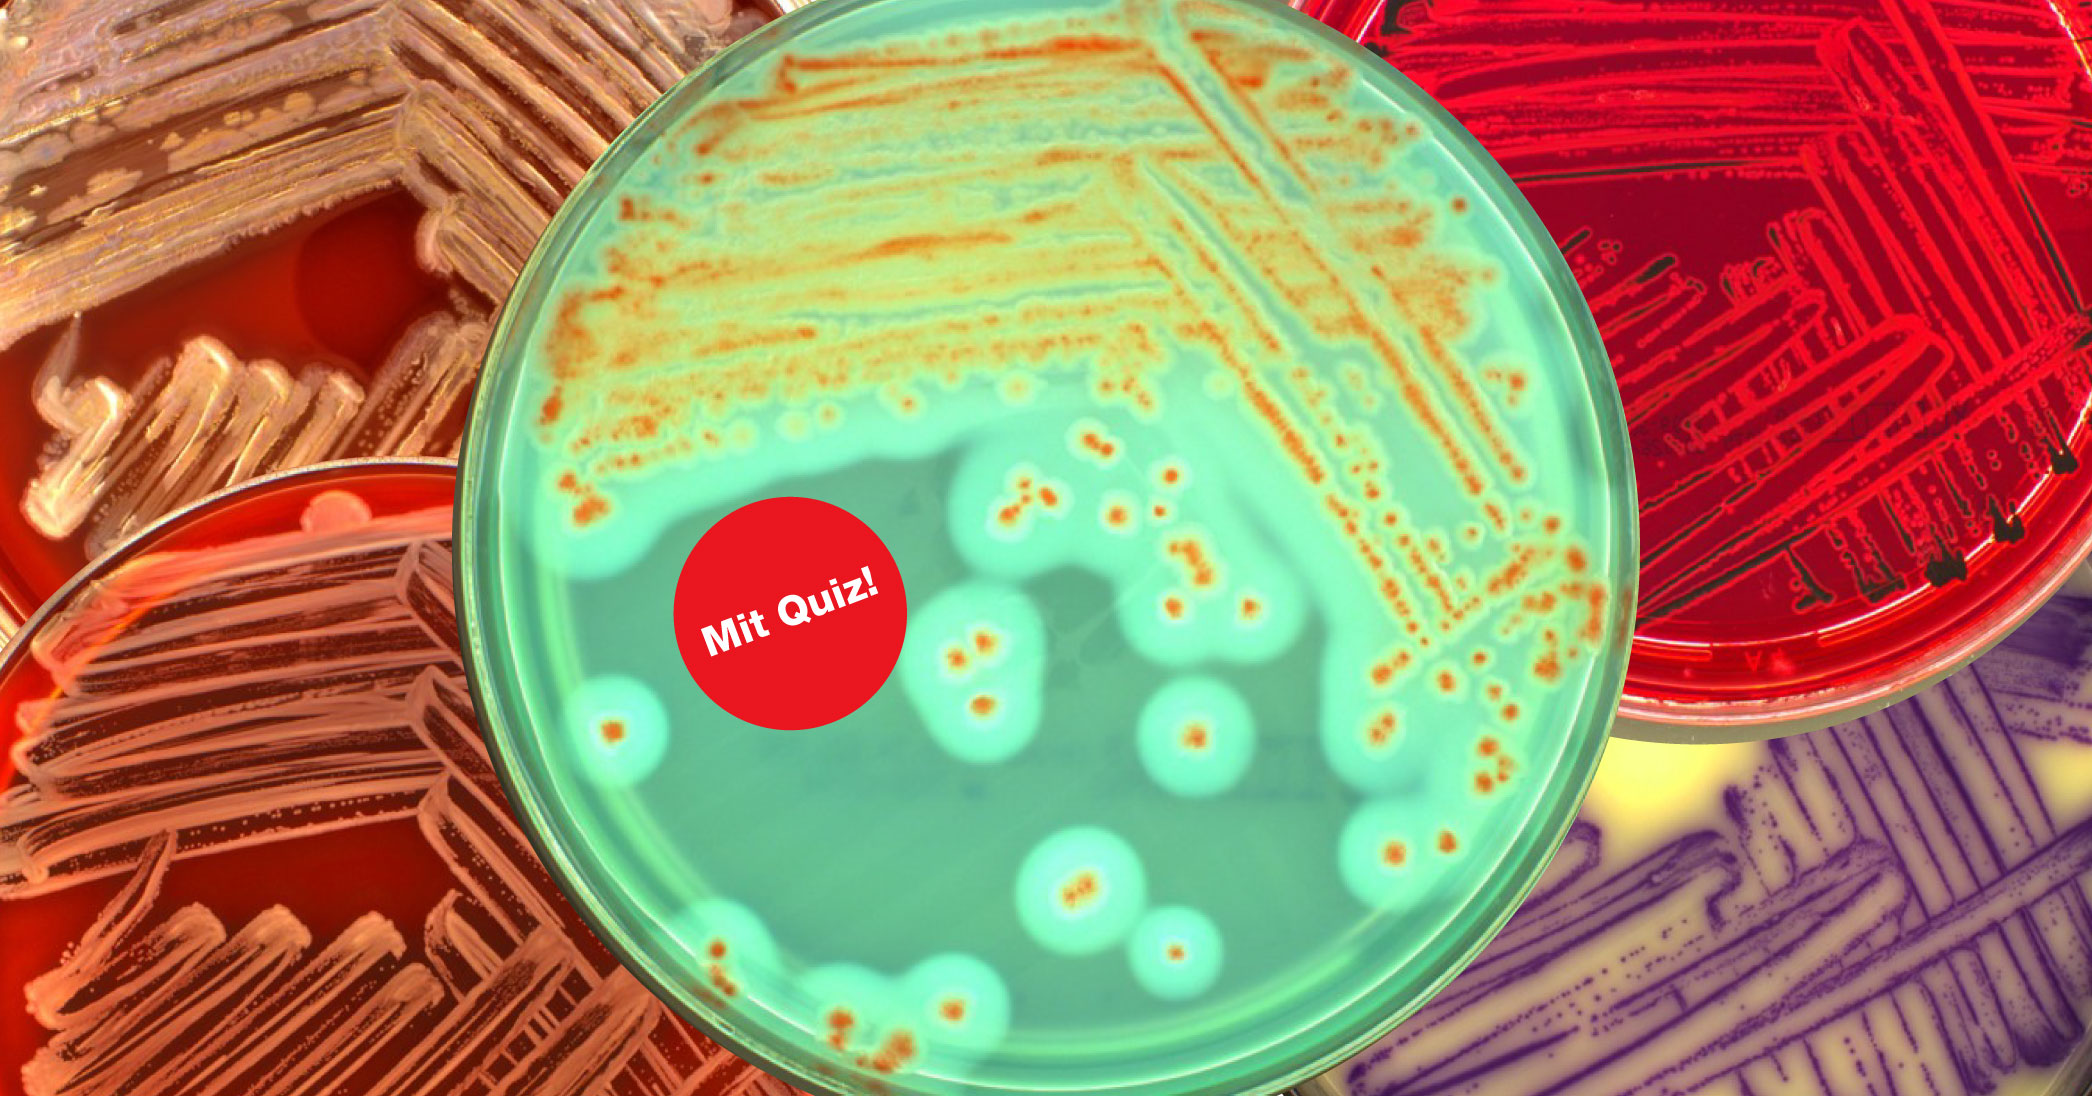

Das Kantonale Laboratorium 2025
Otmar Deflorin, Kantonschemiker Kanton Bern
Editorial

Mit welchen Themen hat sich das Kantonale Laboratorium des Kantons Bern 2025 besonders befasst? Was sind die künftigen Herausforderungen? Und: Kann der Kantonschemiker noch unbeschwert auswärts essen?
Erfahren Sie mehr in den Video-Botschaften von Kantonschemiker Otmar Deflorin.
Im Fokus
Klein aber oho: die verschiedenen Rollen von Mikroorganismen in Lebensmitteln
Bakterien sind nicht per se gut oder schlecht. Manche Bakterien sind durchaus erwünscht und verleihen einem Lebensmittel erst seine besondere Eigenschaft. Im Gegenzug steigen mit der Anzahl verarbeiteter Produkte auch die der mikrobiologischen Gefahren, wie Untersuchungen des Kantonalen Laboratoriums zeigen. Eine kleine Übersicht aus der Praxis.

Die Helfer: Mikroorganismen als Hersteller
Mikroorganismen wie Bakterien oder Hefen sind in der Umwelt weitverbreitet: Sie leben in der Erde, auf Pflanzen und auch auf unserer Haut. Dabei sind nur die wenigsten von ihnen für den Menschen gefährlich, viele davon sind sogar nützlich. Ein gutes Beispiel ist unser Darm: Er wird von Millionen von Mikroorganismen bewohnt, die eine wichtige Rolle bei der Verdauung, der Herstellung von Vitaminen und der Abwehr von Krankheitserregern spielen.
Mikroorganismen verfügen über andere Stoffwechselvorgänge als Menschen. Ihre Fähigkeiten werden deshalb seit jeher genutzt, um Lebensmittel herzustellen oder zu veredeln. Fermentierte Lebensmittel wie Wein, Käse oder Joghurt wären ohne den tatkräftigen Einsatz der kleinen Helfer undenkbar.
Die Unerwünschten: Mikroorganismen als Verderbniserreger
Mikroorganismen können jedoch auch unkontrolliert auf und in Lebensmitteln wachsen und diese dabei verderben. Dies geschieht, wenn Lebensmittel durch unzureichende Hygiene übermässig kontaminiert oder bei zu hohen Temperaturen und zu lange gelagert werden. Besonders gefährdet sind verarbeitete Lebensmittel, die einen idealen Nährboden für mikrobielles Wachstum darstellen.
Aus diesem Grund wurden im Jahr 2025 mehr als 2700 Proben im Rahmen von Betriebsinspektionen erhoben und im Labor mikrobiologisch untersucht. Über 800 Proben überschritten dabei die lebensmittelrechtlichen Höchstwerte und wurden beanstandet.
Zwei Punkte gilt es dabei zu beachten:
- Die Probenerhebung erfolgte risikobasiert. Die hohe Beanstandungsquote erlaubt somit keine direkten Rückschlüsse auf die durchschnittliche Qualität der im Markt angebotenen Lebensmittel.
- Der Grossteil aller Beanstandungen betraf Überschreitungen von mikrobiologischen Richtwerten. Das bedeutet, dass die Hygiene zwar mangelhaft war, eine Gesundheitsgefährdung bestand für die Konsumierenden jedoch nicht.
Mit der zunehmenden Schnelllebigkeit des Alltags und dem Wunsch nach Flexibilität werden auch im Detailhandel immer mehr verarbeitete Produkte angeboten. Mit längeren Haltbarkeitsfristen steigen aber auch die Risiken. Das Kantonale Laboratorium untersuchte deshalb im Jahr 2025 gezielt auch solche Produkte aus dem Handel und aus Gewerbebetrieben. So wurden 30 Proben gekochter Schinken aus dem Detailhandel oder aus Metzgereien untersucht, von denen ein Drittel Richtwertüberschreitungen aufwies. Bei den Abklärungen traten Mängel in den Liefer- und Kühlketten sowie zu optimistische Haltbarkeitsfristen zutage.

Die Gefürchteten: Mikroorganismen als Krankheitserreger
Das Kantonale Laboratorium untersuchte im Jahr 2025 diverse Risikoprodukte auf krankheitserregende Keime wie Salmonellen und Listerien. Während diese Keime bei gesunden Menschen in der Regel unangenehme, jedoch vorübergehende Symptome verursachen, stellen sie insbesondere für YOPIs – Junge (young), Alte (old), Schwangere (pregnant) und Immunsupprimierte (immunocompromised) – eine grosse Gefahr dar.
Der Nachweis dieser Keime zieht in der Regel umfassende Abklärungen und einschneidende Massnahmen für die betroffenen Betriebe nach sich, wie folgendes Beispiel aufzeigt: Im Rahmen einer Querschnittskampagne in Handels- und Gewerbebetrieben wurden in einer Schinkenprobe Bakterien der Art Listeria monocytogenes nachgewiesen. Der betroffene Betrieb wurde unmittelbar nachbeprobt. Dabei wurden weitere Lebensmittel- sowie Umgebungsproben erhoben. In sechs von neun Proben wurden Listerien erneut nachgewiesen. Dem Betrieb wurden umfassende Reinigungs- und Analysenauflagen verfügt. Zudem musste er während der folgenden Monate eigene Untersuchungen zur Freigabe seiner Produkte durchführen.
Fazit: Sicherheit und Qualität durch gezielte Kontrollen
Mikrobiologische Untersuchungen sind ein wichtiges Werkzeug, um versteckte Hygienemängel aufzudecken. Sie tragen nicht nur zur Verbesserung der Lebensmittelsicherheit bei, sondern helfen auch den Betrieben, ihre Produktionsprozesse zu optimieren und so die Qualität ihrer Produkte zu gewährleisten. Das Kantonale Laboratorium spielt eine zentrale Rolle beim Schutz der Konsumentinnen und Konsumenten und sorgt dafür, dass sie sichere Lebensmittel geniessen können.
Zahlen & Fakten
Die Kontrolleurinnen und Kontrolleure des Kantonalen Laboratoriums inspizierten im Jahr 2025 insgesamt 6659 Betriebe und erhoben gut 11 000 Lebensmittel-, Trinkwasser- und Asbestproben.
Tipp: Indem Sie auf die Legenden klicken, blenden Sie einzelne Komponenten aus. So werden auch tiefe Werte sichtbar.
Labortätigkeit
Von tierischen Produkten über Backwaren bis Spielzeuge: Insgesamt hat das Kantonale Laboratorium im letzten Jahr 7816 der Lebensmittelgesetzgebung unterstellte Proben untersucht und lebensmittelrechtlich beurteilt.
Von den 7816 untersuchten Proben mussten 1075 beanstandet werden. In der Grafik werden die Beanstandungsgründe anteilsmässig dargestellt.
Die Probenerhebung für die Untersuchungen erfolgte risikobasiert. Aus diesem Grund lässt die Zusammenstellung keine Rückschlüsse auf die durchschnittliche Qualität der im Markt erhältlichen Lebensmittel zu.
Inspektionstätigkeit
2025 wurden 6659 Lebensmittel- und Trinkwasserbetriebe überprüft. In 230 Fällen wurde Strafanzeige eingereicht (2024: 198). Sieben Betriebe mussten geschlossen werden (2024: 7).
Nach jeder Inspektion werden die Ergebnisse bewertet und der Betrieb in eine der Gesamtgefahren «unbedeutend», «klein», «erheblich» oder «gross» eingeteilt. Damit wird risikobasiert der nächste Inspektionstermin festgelegt.
Betriebe mit einer kleinen Gesamtgefahr werden weniger häufig kontrolliert als solche mit einer grossen Gesamtgefahr.
Proben- und Inspektionsstatistik 2025
Im Labor
Auf der Suche nach Asbest
Asbest wurde häufig im Bauwesen eingesetzt. Aufgrund erheblicher Gesundheitsgefahren ist die Verwendung in der Schweiz seit 1990 verboten. Besteht bei einem Umbau der Verdacht auf Asbest, gilt es umgehend eine Fachperson hinzuzuziehen. Das KL untersucht jährlich rund 2000 Proben auf Asbest.
Erfahren Sie mehr in der Bildergalerie:
 Bei sämtlichen Bauarbeiten ist die Bauherrschaft für den korrekten Umgang mit Bauschadstoffen verantwortlich. Bei Gebäuden, die vor 1990 oder früher erstellt wurden, muss mit Asbest gerechnet werden. Dies ist vor Bauarbeiten zu prüfen.
Bei sämtlichen Bauarbeiten ist die Bauherrschaft für den korrekten Umgang mit Bauschadstoffen verantwortlich. Bei Gebäuden, die vor 1990 oder früher erstellt wurden, muss mit Asbest gerechnet werden. Dies ist vor Bauarbeiten zu prüfen. Asbest ist ein Gefahrstoff. Bei der Probenahme ist Vorsicht geboten: FFP3-Feinstaubmaske, Schutzbrille und Handschuhe sind nötig. Die Probe muss alle Schichten des verdächtigen Materials enthalten und ca. 5-Fränkler bis handflächengross sein. Bild: SUVA.
Asbest ist ein Gefahrstoff. Bei der Probenahme ist Vorsicht geboten: FFP3-Feinstaubmaske, Schutzbrille und Handschuhe sind nötig. Die Probe muss alle Schichten des verdächtigen Materials enthalten und ca. 5-Fränkler bis handflächengross sein. Bild: SUVA. Alle Proben müssen einzeln in luftdichte Säcke verpackt und genau beschriftet werden. Anschliessend können sie im Kantonalen Laboratorium direkt am Schalter oder per Post eingereicht werden.
Alle Proben müssen einzeln in luftdichte Säcke verpackt und genau beschriftet werden. Anschliessend können sie im Kantonalen Laboratorium direkt am Schalter oder per Post eingereicht werden. Sobald die Probe im Labor eingeht, wird sie im System erfasst und von einer Fachperson geprüft. Diese ordnet sie einem Typ zu und legt die erforderlichen Schritte für die weitere Aufbereitung fest.
Sobald die Probe im Labor eingeht, wird sie im System erfasst und von einer Fachperson geprüft. Diese ordnet sie einem Typ zu und legt die erforderlichen Schritte für die weitere Aufbereitung fest. Asbest-Experte Kevin Pinatrić vom Kantonalen Laboratorium zeigt Schritt für Schritt, wie eine Probe getestet wird und was es dabei zu beachten gilt.
Asbest-Experte Kevin Pinatrić vom Kantonalen Laboratorium zeigt Schritt für Schritt, wie eine Probe getestet wird und was es dabei zu beachten gilt. Um das Laborpersonal vor freigesetzten Asbestfasern zu schützen, finden alle Arbeiten mit den Proben in sogenannten Laborkapellen mit gefilterter Abluft statt.
Um das Laborpersonal vor freigesetzten Asbestfasern zu schützen, finden alle Arbeiten mit den Proben in sogenannten Laborkapellen mit gefilterter Abluft statt.
Wissenswertes rund um Asbest
Was genau ist Asbest?
Unter Asbest versteht man verschiedene, natürlich vorkommende faserig gewachsene Minerale.
Warum war Asbest so beliebt?
Aufgrund seiner ausgeprägten Biege- und Zugfestigkeit, der hohen Hitzebeständigkeit, der chemischen Resistenz und thermischen Isoliereigenschaften galt Asbest lange als idealer Baustoffzusatz. Zudem lassen sich Asbestfasern gut mit Zement oder Kunststoff verarbeiten. Deshalb wurden bis zum Verbot 1990 zahlreiche asbesthaltige Materialien verbaut. Dazu gehören etwa Eternitplatten, Fliesenkleber, Fensterkitte, Bodenbeläge, Isolationen, Dichtungen und Putze.
Warum wurde der Gebrauch von Asbest in der Schweiz verboten?
Asbestfasern können fatale Folgen haben, wenn sie eingeatmet werden. Die dadurch verursachten Erkrankungen treten oft erst Jahrzehnte später auf.
Wann ist Asbest gefährlich?
Asbest ist in vielen Gebäuden zu finden und meist ungefährlich, solange keine Eingriffe stattfinden. Gefährlich ist Asbest vor allem dann, wenn Umbau-, Renovations- oder Abbrucharbeiten vorgenommen und so Fasern freigesetzt und eingeatmet werden. Besonders gefährdet sind daher Personen aus dem Bau- und Handwerksbereich.
Wann müssen Proben ins Labor geschickt werden?
Vor 1990 errichtete Bauten und Anlagen können Asbest enthalten. Vor baulichen Eingriffen muss deshalb verdächtiges Material analysiert und gegebenenfalls entfernt werden. Für die Untersuchung empfiehlt das Forum Asbest Schweiz Analyselabors wie etwa das Kantonale Laboratorium Bern.
Mehr Informationen zum Thema Asbest:
Quiz: Testen Sie Ihr Labor-Wissen
Welches Lebensmittel verdirbt am leichtesten? Und welche kuriose Verwendung von Asbest gab es im 20. Jahrhundert?
Über uns

Das Kantonale Laboratorium (KL) ist eine Amtsstelle der Wirtschafts-, Energie- und Umweltdirektion (WEU) und beschäftigt rund 70 Mitarbeitende.
Das KL ist zuständig für die Kontrolle von Lebensmitteln und Lebensmittelbetrieben, von Gebrauchsgegenständen wie Geschirr, Kosmetika und Spielzeug, Bade- sowie Trinkwasser. Zudem überwacht es die Landwirtschafts-, Umweltschutz-, Chemikalien- und Strahlenschutzgesetzgebung mit gezielten Stichproben.
Informationen
Mehr zu den detaillierten Untersuchungsergebnissen erfahren Sie in den folgenden Dokumenten.